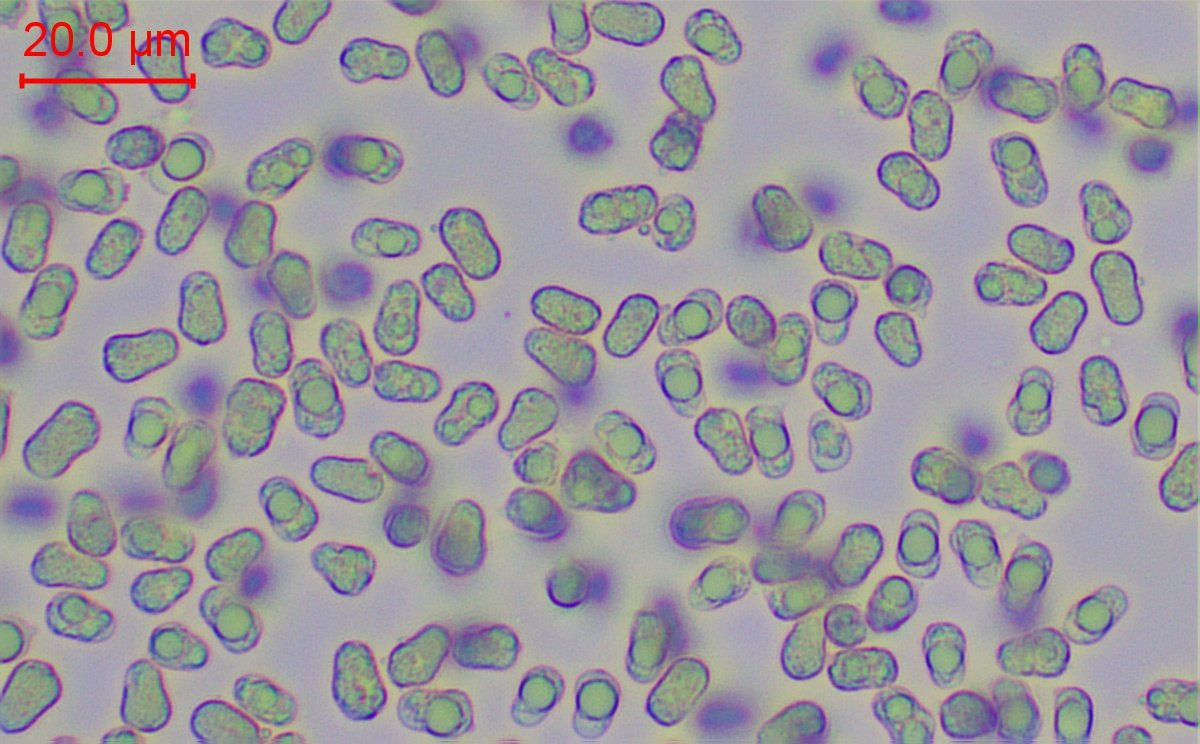

Page 1 sur 1
Hygrocybe savernois
Posté : 15 oct. 2024, 06:35
par Fouad
Bonjour,
Une récolte d'hier sur sol sablonneux. Feuillus et conifères.
Je pense qu'il s'agit de la même espèce que
celle de Bastic postée hier?
N= 20 ; 8 (10) x 5,7 µ ; Qm= 1,59
Re: Hygrocybe savernois
Posté : 15 oct. 2024, 10:27
par Jplm
Il y a deux ou trois espèces à spores comprimées dans le Boertmann mais la macro + le sol orientent bien vers constrictispora.
Jplm
Re: Hygrocybe savernois
Posté : 16 oct. 2024, 08:47
par Bastic
Salut !
Silhouette plate, lames adnées, revêtement squamuleux à squames concolores : sous section Squamulosineae.
On dirait des poires, tes spores, pour certaines.
Hygrocybe miniata ?
Re: Hygrocybe savernois
Posté : 16 oct. 2024, 09:14
par Jplm
J'avais remarqué le revêtement un peu grenu mais peut-on parler de "squamuleux" ? Au grossissement tout parait grenu, même la peau d'un bébé. Regarde ta photo
là, en agrandissant ils ne sont pas non plus 100% lisses.
C'est ce que je disais en parlant d'appréciation : dans ces hygrocybes colorés, on est toujours dans le
plus ou moins jaune/orange/rouge, dans le
plus ou moins grenu, dans des lames
plus ou moins blanches/jaunes/bordées/décurrentes etc. Même les spores sont
plus ou moins étranglées ! Quand on essaye de faire entrer ça dans une, clé on arrive
plus ou moins n'importe où...
Jplm
Re: Hygrocybe savernois
Posté : 16 oct. 2024, 17:49
par Fouad
Sur le groupe de la SMS, on s'y oppose pas à l'idée de JPLM. Je renomme en le remerciant ;)
Re: Hygrocybe savernois
Posté : 27 oct. 2024, 23:07
par Richmond63
Je pense que Bastic avait vu juste sur cette récolte que je découvre.
Pour moi, je suis certainement en faveur de miniata, ce chapeau est bien squamuleux, les lames sont adnées, constrictospora a des lames décurrentes et un chapeau lisse. les spores matchent bien avec miniata, Q = 1.6, l'autre les a plus longues et un peu plus étroites avec un Q moyen de 1.85.
Re: Hygrocybe savernois
Posté : 28 oct. 2024, 06:57
par Fouad
Bonjour,
Merci Richard. Je n'ai pas de littérature précise sous la main. Mes spores sont en majorité de largeur supérieur à la fourchette donnée pour miniata 4,5-5 µ contre 5,7 en moyenne ici ?
Re: Hygrocybe savernois
Posté : 28 oct. 2024, 12:01
par Richmond63
Justement ! Tu abondes dans mon sens : constrictospora [4 - 4.5 (5) - Boertmann].
Re: Hygrocybe savernois
Posté : 28 oct. 2024, 16:11
par Fouad
Je corrige alors ;)